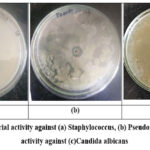

Microbial Melanin from Pseudomonas Species: Extraction, Characterization, and Multifunctional Applications
1Department of Microbiology, M.C.E Society’s, Abeda Inamdar Senior College, Pune, India.
2Department of Chemistry, M.C.E Society’s, Abeda Inamdar Senior College, Pune, India.
Corresponding Author E-mail:: jaspaloberoi@azamcampus.org
DOI : http://dx.doi.org/10.13005/bbra/3508
ABSTRACT:Melanin pigments are versatile biomolecules with significant pharmaceutical, environmental, and biotechnological relevance. In this study, rhizospheric soil sample from campus was screened on tyrosine agar medium to isolate melanin-producing microorganisms. The most efficient isolate was identified as Pseudomonas species through biochemical characterization. Production parameters, including L-tyrosine concentration (0.1–1%), nitrogen sources, and vitamin supplementation, were systematically optimized to enhance pigment yield in which the 1% L tyrosine and yeast extract as nitrogen source showed high pigmentation production. The extracted melanin was purified and characterized using FTIR spectroscopy, confirming its eumelanin nature. The biofunctional potential of the pigment was assessed through antimicrobial assays against (Staphylococcus spp., Pseudomonas spp., and Candida albicans), antioxidant activity (DPPH radical scavenging) and heavy metal chelation. The Pseudomonas-derived melanin exhibited strong antioxidant activity, good antimicrobial efficacy, excellent chelation capacity for lead and cadmium. These findings highlight microbial melanin as a promising bioresource with multifunctional applications. Refinement of extraction and purification protocols may further augment its bioactivity, enabling targeted utilization in pharmaceutical, environmental, and industrial sectors.
KEYWORDS:Antioxidant activity; Heavy metal bioremediation; Microbial melanin; Pseudomonas species; Rhizospheric soil microorganisms
Introduction
Color represents one of nature’s most eloquent expressions of diversity, adaptation, and survival.1 Beyond aesthetics, it reflects intricate biochemical and evolutionary processes essential to life.2 Among natural pigments, melanin stands out as a complex, multifunctional biopolymer with diverse biological and physicochemical roles. Produced by microorganisms, plants, animals, and humans, melanin functions as a natural shield against ultraviolet (UV) radiation, oxidative stress, and other environmental hazards.3 Owing to its remarkable properties and wide-ranging applications, microbial melanin has attracted increasing attention in biotechnology.4,5
Synthetic dyes have long dominated industries like textiles, food, cosmetics, and pharmaceuticals, but their toxic, non‑biodegradable nature raises serious ecological and health concerns. This has driven interest in microbial pigments as sustainable alternatives.6 Microorganisms such as bacteria, fungi, algae, and yeast can produce diverse pigments year‑round using inexpensive substrates, including waste materials. Unlike plant or animal sources, microbial pigments are not limited by season or geography and often provide added bioactivities such as antioxidant, antimicrobial, anticancer, and UV‑protective effects.7,8,9
Among microbial pigments, melanin is one of the most chemically complex and functionally versatile biomolecules. Derived from the Greek melanos (“black”), melanins are high-molecular-weight aromatic polymers formed by oxidative polymerization of phenolic or indolic precursors such as L-tyrosine or dopamine.10 They are broadly classified into eumelanin (black-brown), pheomelanin (red-yellow, sulfur-containing), allomelanin (nitrogen-free), pyomelanin (water-soluble brown pigment from homogentisic acid), and neuromelanin.11,12 In microorganisms, eumelanin and pyomelanin are most prevalent, typically synthesized via tyrosinase-catalyzed oxidative pathways, conferring protection against radiation, oxidative stress, and heavy metal toxicity.13 14
Microbial melanin production offers distinct advantages over conventional sources such as sepia ink or animal tissues, which involve complex, costly, and low-yield extraction.15 Microbial systems enable rapid growth, predictable yields, and scalable production. Factors such as precursor concentration, nitrogen source, salinity, and pH strongly influence biosynthesis,16 while advances in bioprocess optimization and metabolic engineering have further enhanced yields and enabled tailoring of melanin properties for specific applications.17
Among microbial pigment producers, Pseudomonas species stand out due to their metabolic versatility and wide distribution in soil, water, and rhizospheres. Many strains synthesize pyomelanin via the homogentisic acid pathway or eumelanin through tyrosinase‑mediated oxidation of L‑tyrosine. Their adaptability to diverse environments and ability to utilize varied substrates make them strong candidates for industrial‑scale pigment production.18, 19, 20
Structurally, melanin is a heterogeneous polymeric network of indolic and phenolic monomers interconnected through covalent and non-covalent interactions.21 This architecture imparts exceptional thermal stability, chemical resistance, and broadband light absorption from UV to near-infrared wavelengths. Functionally, melanin acts as a potent free radical scavenger, metal chelator, and radiation absorber, enhancing microbial survival under desiccation, salinity, and radiation stress 22,23 In pathogenic strains, melanin can also contribute to virulence by suppressing host immune responses and promoting biofilm formation.23
Beyond its biological roles, melanin has been explored for biomedical applications such as antioxidant formulations, drug delivery, tissue engineering, photoacoustic imaging, and wound healing.24 In environmental biotechnology, its ability to chelate heavy metals and adsorb organic pollutants makes it a promising biomaterial for wastewater treatment and bioremediation.25 Its semiconducting and photothermal properties have also sparked interest in organic electronics, energy storage, and biosensors, while cosmetic and agricultural uses continue to expand.26
Systematic studies on bacterial melanin remain limited, particularly in linking production optimization, structural characterization, and bioactivity evaluation. Since pigment yield depends on precursor supply, nutrient balance, and environmental conditions, and properties vary with microbial origin, detailed characterization is essential to ensure reproducible and application‑specific outcomes.27
This study focuses on the extraction and characterization of melanin pigment from Pseudomonas species isolated from rhizospheric soil. Production parameters, including L‑tyrosine concentration, nitrogen source variation and vitamin supplementation, were optimized to enhance pigment yield. The purified pigment was structurally characterized using Fourier Transform Infrared (FTIR) spectroscopy to confirm functional groups associated with melanin, and its biofunctional potential was evaluated through antioxidant (DPPH assay), antimicrobial, and heavy metal bioremediation studies. These findings contribute to microbial pigment biotechnology and support the sustainable utilization of Pseudomonas-derived melanin in pharmaceuticals, environmental management, and materials science.
Materials and Methods
Collection of Soil Samples and Isolation of Melanin-Producing Bacteria
Soil samples were collected from Azam Campus in Pune (18.503° N Latitude and 73.875° E Longitude) using sterile spatulas and stored in sterile containers. Serial dilutions were prepared in sterile saline solution, and aliquots were spread onto Tyrosine Agar Medium (TAM). The composition of TAM is 0.5% L- tyrosine in nutrient agar. The medium is supplemented with L-tyrosine as a precursor for melanin biosynthesis. Plates were incubated at 30 ± 2 °C for 5–7 days on shaker incubator at 120 rpm. Colonies exhibiting brown to dark-brown pigmentation, either within or diffusing into the surrounding medium, were considered potential melanin producers and were repeatedly sub-cultured to obtain pure isolates.28
Screening and Selection of Potent Melanin-Producing Isolate
Pigmented isolates were screened based on the intensity and diffusion of pigmentation on TAM. The isolate producing the most intense dark-brown pigment was selected as the potent melanin producer and preserved on nutrient agar slants at 4 °C for subsequent studies.28
Morphological and Biochemical Characterization of the Isolate
The selected isolate was subjected to Gram staining and microscopic examination to determine cell morphology and motility. Standard biochemical tests were performed, including Oxidase, Catalase, Citrate, Indole, Methyl red and Sugar utilisation assays with glucose, fructose, maltose, sucrose, raffinose, and xylose. The isolate was identified as a Pseudomonas species based on Gram-negative, rod-shaped, motile characteristics and metabolic versatility.29
Optimization of Culture Conditions for Melanin Biosynthesis
Effect of L-Tyrosine Concentration
The effect of L-tyrosine concentration (0.1–1%, w/v) on melanin production was studied by supplementing the production medium accordingly. Cultures were incubated at 30 °C for 7 days, and pigment intensity was visually assessed. The concentration yielding maximum pigmentation was considered optimal.
Effect of Nitrogen Sources
Different nitrogen sources (beef extract, yeast extract, peptone) were individually incorporated into the production medium. Pigment production was evaluated after incubation to determine its influence on melanin biosynthesis.
Effect of Vitamin Supplementation
The Vitamin supplementation was studied by adding 0.1% vitamin A to the medium. Pigment intensity was compared with control cultures to evaluate enhancement or inhibition.30
Production, Extraction, and Purification of Melanin Pigment
The optimized production medium was inoculated with the potent isolate and incubated under optimized conditions for 7 days. After incubation, the culture broth was centrifuged at 10,000 rpm for 15 min to remove bacterial cells. The supernatant was acidified to pH 2.0 using 6 N HCl to precipitate melanin. The precipitate was collected by centrifugation, washed repeatedly with distilled water, ethanol, and acetone to remove impurities, and dried to obtain a black-brown melanin powder.31
Solubility Testing and Preliminary Characterization of Melanin
The purified melanin was tested for solubility in distilled water, ethanol, methanol, chloroform, alkaline and acidic solutions. Insolubility in organic solvents and solubility in alkaline solutions were used as confirmatory characteristics of melanin pigment.32
Antimicrobial Activity of Melanin
The antimicrobial activity of the extracted melanin was evaluated against Gram-positive bacteria (Staphylococcus spp.), Gram-negative bacteria (Pseudomonas spp.), and the fungus Candida albicans. The assay was performed using the agar well diffusion method. Sterile nutrient agar plates for bacteria and Sabouraud dextrose agar plates for fungi were inoculated with standardized microbial suspensions adjusted to 0.5 McFarland standard. Wells were aseptically bored into the agar plates, and melanin solutions were added to the wells. The plates were incubated at 37 °C for 24 h for bacterial strains and at 28 °C for 48 h for fungal strains. The antimicrobial activity was determined by measuring the zone of inhibition around each well.33
Evaluation of Antioxidant Potential via DPPH Radical Scavenging Assay
The antioxidant potential of purified melanin was evaluated using the DPPH (2,2-diphenyl-1-picrylhydrazyl) radical scavenging assay. Various concentrations of melanin (7.81–500 mg/ml) were prepared. Each sample (1 ml) was mixed with 1 ml of freshly prepared DPPH solution and incubated in the dark at room temperature for 30 minutes. Absorbance was measured at 517 nm using a UV–Visible spectrophotometer. Ascorbic acid was used as a standard antioxidant.34
Formula for Antioxidant Activity:
Assessment of Heavy Metal Chelation Capacity
The metal-binding ability of melanin was evaluated using Lead, Cadmium, Zinc & Copper metal. Known concentrations of metal ion solutions were incubated with purified melanin for 04 days at room temperature. Residual ion concentration was measured spectrophotometrically, and a reduction in concentration indicated chelation efficiency.35
Results
Screening and Isolation of Melanin-Producing Microorganisms
1 g of soil sample was used for microbial isolation. Depending on the efficiency of the isolate and culture conditions, microbial melanin yield was 50–200 mg/L. Screening of samples on tyrosine agar medium (TAM) resulted in the development of several pigmented colonies. Among these, one isolate exhibited intense brown–black pigmentation, indicating significant melanin production. The pigment production was further evaluated by quantitative estimation using UV–Visible spectrophotometry. Based on its superior pigment yield, this isolate was selected for further studies.36
Identification of the Potent Melanin-Producing Isolate
The microscopic and biochemical characterization of the selected isolate (Figure 1) revealed that it was Gram-negative, rod-shaped, and motile. The organism showed positive result with Oxidase, Catalase and Citrate whereas Indole and Methyl red test were negative. The isolate showed the ability to utilize multiple carbon sources, including glucose, fructose, maltose, sucrose, and raffinose, while limited utilization of xylose was observed as shown in table 1. Based on these morphological and biochemical characteristics, the isolate was tentatively identified as a Pseudomonas species.37
Table 1: Biochemical characterization of the isolate
| Characteristic | Result |
| Gram Nature | Gram negative |
| Motility | motile |
| Oxidase | +ve |
| Catalase | +ve |
| Citrate | +ve |
| Indole | -ve |
| Methyl red | -ve |
| Sugar utilisation | glucose, fructose, maltose, sucrose, and raffinose |
![]() |
Figure 1: (a) melanin production in broth, (b) Extracted and purified Melanin, (c) Melanin producing colonies on agar medium
|
Optimization of Physicochemical Parameters for Melanin Production
Melanin production was evaluated at varying L-tyrosine concentrations (0.1–1%). Maximum pigment yield was observed at 0.5% L-tyrosine. Among the nitrogen sources tested, beef extract and yeast extract significantly enhanced melanin production compared to peptone. The supplementation with vitamin A (0.1%) resulted in a slight increase in pigment intensity (Table 2).38
Table 2: Optimization of culture conditions on melanin production
| Parameter | Condition | Concentration | Observation (Melanin Production) |
| L-Tyrosine Concentration | Precursor supplementation | 0.1% | Low pigmentation |
| 0.25% | Moderate pigmentation | ||
| 0.5% | High pigmentation | ||
| 0.75% | Very high pigmentation | ||
| 1.0% | Maximum pigmentation | ||
| Nitrogen Source | Beef extract | — | Moderate melanin production |
| Yeast extract | — | High melanin production | |
| Peptone | — | Moderate production | |
| Vitamin Supplementation | Vitamin A | 0.1% | Low pigmentation |
Extraction, Purification, and Characterization of Melanin
The extracted pigment appeared as a fine black–brown powder. Solubility analysis showed that the pigment was soluble in alkaline solutions and DMSO but insoluble in water, methanol, ethanol, and acidic media (Table 3). During purification, the pigment was washed with distilled water to remove water-soluble impurities, followed by 95% ethanol to eliminate lipid residues and acetone to remove other organic impurities. Finally, a wash with distilled water was performed before drying the pigment.39
Table 3: Solubility of melanin in various solvents (+) Soluble (-) Insoluble
| Solvent | 0.5 to 2.5M NaOH | 0.5 to 2.5M HCl | DMSO | Methanol | Ethanol | Water |
| Solubility of melanin | + | – | + | – | – | – |
FTIR spectroscopy (Figure 2) confirmed the pigment as eumelanin, with characteristic absorption peaks at 3372 cm⁻¹ (–OH/–NH stretching), 1633 cm⁻¹ (C=O stretching), 1323 cm⁻¹ (C–N stretching), and 1153 cm⁻¹ (C–O stretching), indicating an indolic polymeric structure derived from L-tyrosine.40
![]() |
Figure 2: FTIR graph of Isolated Melanin
|
Antimicrobial Activity of Melanin
Crude melanin exhibited inhibitory activity against both Gram-positive and Gram-negative bacteria, including Staphylococcus spp. and Pseudomonas spp. Antifungal activity was also observed against Candida albicans, as indicated by measurable zones of inhibition (Figure 3, Table 4).
Table 4: Antimicrobial activity of extracted melanin.
| Microorganism | Observed Activity | Remark |
| Staphylococcus | Clear, well-defined zone, highly sensitive | Antibacterial activity present |
| Pseudomonas | Clear, well-defined zone, sensitive | Antibacterial activity present |
| Candida albicans | Clear zone | Antifungal activity present |
![]() |
Figure 3: Antibacterial activity against (a) Staphylococcus, (b)Pseudomonas & antifungal activity against (c)Candida albicans
|
Antioxidant Activity (DPPH Radical Scavenging)
The DPPH radical scavenging assay revealed strong antioxidant activity of melanin. At concentrations ranging from 7.81 to 500 mg/ml, melanin showed an increase in absorbance, in this assay a clear inverse relationship was observed between concentration of melanin sample and absorbance. As the concentration of the sample increased, the absorbance values decreased, reflecting greater scavenging of DPPH radicals. Positive control was ascorbic acid (Table 5).41
Table 5: Antioxidant Activity of Melanin at different concentrations
| Concentration (mg/ml) | 500 | 250 | 125 | 62.5 | 31.25 | 15.62 | 7.81 | Control |
| Absorbance of isolated melanin | 0.168 | 0.23 | 0.289 | 0.341 | 0.39 | 0.436 | 0.456 | 0.800 |
Heavy Metal Bioremediation Potential
Melanin demonstrated effective chelation of heavy metals, particularly Pb²⁺ and Cd²⁺ ions. Heavy metal absorption was measured using a UV–Visible spectrophotometer. The decrease in metal ion concentration in solution after exposure to melanin indicated the extent of absorption. A significant reduction in metal ion concentration was observed over the incubation period, indicating strong biosorption capacity (Table 6, Figure 4).
Table 6: Heavy metal absorption for isolated melanin
| Days | Day 0 | Day 1 | Day 2 | Day 3 | Day 4 |
| Lead | 0.25 | 0.152 | 0.008 | 0.004 | 0.002 |
| Cadmium | 0.254 | 0.122 | 0.119 | 0.112 | 0.047 |
| Zinc | 0.013 | 0.423 | 0.562 | 0.665 | 0.719 |
| Copper | 0.209 | 0.205 | 0.381 | 0.333 | 0.380 |
![]() |
Figure 4: Graph for Heavy metal absorption for isolated melanin
|
Discussion
The isolation of a potent melanin-producing Pseudomonas species from soil highlights the remarkable metabolic adaptability of soil-associated bacteria. The intense pigmentation observed on tyrosine agar medium is consistent with earlier reports identifying Pseudomonas as an efficient producer of microbial melanin, particularly due to its versatile tyrosinase activity.42 Such findings reinforce the ecological significance of soil bacteria as reservoirs of bioactive pigments.
Optimization studies revealed that melanin biosynthesis is strongly influenced by precursor concentration and nutrient composition. Maximum pigment yield at 1% L-tyrosine suggests optimal tyrosinase activity at this concentration, whereas reduced production at higher levels may reflect substrate inhibition. Similar substrate-dependent regulation has been reported in Bacillus and Streptomyces species, where excess precursor leads to feedback inhibition of pigment synthesis.43 Enhanced pigment synthesis in the presence of beef extract and yeast extract (Table 2) underscores the importance of complex nitrogen sources and growth factors, aligning with studies that emphasize the role of organic nitrogen in supporting secondary metabolite productions.44
The FTIR spectrum of the extracted pigment (Figure 2) showed characteristic absorption bands typical of eumelanin. A broad peak at 3372 cm⁻¹ corresponds to –OH and –NH stretching vibrations, indicating the presence of phenolic and indolic groups. The band at 1633 cm⁻¹ is attributed to C=O stretching and aromatic C=C vibrations, which are commonly observed in indole-based melanin structures. The peak at 1323 cm⁻¹ corresponds to C–N stretching, while the band at 1153 cm⁻¹ is associated with C–O stretching vibrations, suggesting the presence of oxygen-containing functional groups. These functional groups are consistent with the indolic polymeric structure of eumelanin derived from L-tyrosine. Comparable FTIR profiles have been reported for melanin extracted from Aspergillus fumigatus and Cryptococcus neoformans, confirming the universality of these spectral features in microbial melanin.45
The antimicrobial activity (Table 4, figure 3) demonstrated against both bacterial and fungal pathogens reinforce melanin’s role as a protective biomolecule. This activity may be attributed to its redox properties, metal ion chelation, and interference with microbial metabolic processes, as previously reported in fungal melanins. In addition, melanin exhibited strong antioxidant activity, comparable to that of ascorbic acid. The presence of hydroxyl and indole groups likely contributes to its free radical scavenging capacity through electron or hydrogen donation. Similar antioxidant potential has been documented in melanin from Streptomyces glaucescens, supporting its pharmaceutical relevance.46
The significant chelation of Pb²⁺ and Cd²⁺ ions (Table 6) further highlight the bioremediation potential of Pseudomonas-derived melanin. Functional groups such as carboxyl, hydroxyl, and amino moieties facilitate stable metal complex formation, positioning melanin as a promising, eco-friendly biosorbent for heavy metal detoxification. Comparable studies have demonstrated effective biosorption of heavy metals by fungal melanins, reinforcing the cross-kingdom utility of melanin in environmental applications.47
These findings establish Pseudomonas-derived melanin as a multifunctional biopolymer with broad potential in biomedical, environmental, and industrial applications. Its combined antimicrobial, antioxidant and metal-chelating properties underscore its value as a natural product with significant translational relevance. The results not only corroborate previous literature but also expand the scope of microbial melanin research by demonstrating its multifunctionality in a single bacterial isolate.
Conclusion
The study demonstrates the potential of a soil-derived Pseudomonas species as a reliable microbial source of eumelanin with diverse functional attributes. The successful optimization of culture conditions and confirmation of pigment identity establishes a reproducible framework for microbial melanin production. Rather than functioning as a passive pigment, the extracted melanin exhibited multiple biologically relevant properties, highlighting its functional versatility as a natural biopolymer.
The combination of antimicrobial, antioxidant and metal-binding activities underscores the broader biological and environmental relevance of microbial melanin. Such multifunctionality reflects the inherent chemical complexity of melanin and supports its emerging importance beyond pigmentation, particularly in sustainable and bio-based applications.
Overall, this work contributes to the growing understanding of bacterial melanin as a value-added biomaterial and reinforces the significance of microbial systems as scalable and eco-friendly platforms for functional biopolymer production. Continued refinement of production strategies and targeted application-based evaluations may further enhance its translational potential.\
Acknowledgement
The authors would like to thank Abeda Inamdar Senior College of Arts, Commerce and Science for providing infrastructure & lab facility.
Funding Sources
The author(s) received no financial support for the research, authorship, and/or publication of this article.
Conflict of Interest
The authors do not have any conflict of interest.
Data Availability Statement
This statement does not apply to this article.
Ethics Statement
This research did not involve human participants, animal subjects, or any material that requires ethical approval.
Informed Consent Statement
This study did not involve human participants, and therefore, informed consent was not required.
Clinical Trial Registration
This research does not involve any clinical trials.
Permission to reproduce material from other sources
Not Applicable
Author Contributions
Jaspal Kaur Oberoi: Conceptualization, Methodology, Original Draft
Nazia Tambat: Review & Editing
Shaiba Shaikh & Atoshi Tripathi: Data Collection, Analysis
Shilpa Tambe and Nisha Parween Shaikh: Writing Methodology & Editing
References
- Kratochwil CF, Mallarino R. Mechanisms Underlying the Formation and Evolution of Vertebrate Color Patterns. Annu Rev Genet. 2023;57(1):135-156. doi:10.1146/annurev-genet-031423-120918
CrossRef - El-Zawawy NA, Kenawy ER, Ahmed S, El-Sapagh S. Bioproduction and optimization of newly characterized melanin pigment from Streptomyces djakartensis NSS-3 with its anticancer, antimicrobial, and radioprotective properties. Microb Cell Fact. 2024;23(1):23. doi:10.1186/s12934-023-02276-y
CrossRef - Brenner M HVJ. The protective role of melanin against UV damage in human skin. Photochem Photobiol. 2008;84(3):539-549. doi:10.1111/j.1751-1097.2007.00226
CrossRef - Muñoz-Torres P, Cárdenas-Ninasivincha S, Aguilar Y. Exploring the Agricultural Applications of Microbial Melanin. Microorganisms. 2024;12(7):1352. doi:10.3390/microorganisms12071352
CrossRef - Park S, Lee C, Lee J, Jung S, Choi KY. Applications of Natural and Synthetic Melanins as Biosorbents and Adhesive Coatings. Biotechnology and Bioprocess Engineering. 2020;25(5):646-654. doi:10.1007/s12257-020-0077-7
CrossRef - Ardila-Leal LD, Poutou-Piñales RA, Pedroza-Rodríguez AM, Quevedo-Hidalgo BE. A Brief History of Colour, the Environmental Impact of Synthetic Dyes and Removal by Using Laccases. Molecules. 2021;26(13):3813. doi:10.3390/molecules26133813
CrossRef - Ramesh C, Prasastha VR, Venkatachalam M, Dufossé L. Natural Substrates and Culture Conditions to Produce Pigments from Potential Microbes in Submerged Fermentation. Fermentation. 2022;8(9):460. doi:10.3390/fermentation8090460
CrossRef - Fried R, Oprea I, Fleck K, Rudroff F. Biogenic colourants in the textile industry – a promising and sustainable alternative to synthetic dyes. Green Chemistry. Royal Society of Chemistry. 2022;24(1):13-35. doi:10.1039/d1gc02968a
CrossRef - Yadav S, Tiwari KS, Gupta C, Tiwari MK, Khan A, Sonkar SP. A brief review on natural dyes, pigments: Recent advances and future perspectives. Results Chem. 2023;5:100733. doi:10.1016/j.rechem.2022.100733
CrossRef - Tran-Ly AN, Reyes C, Schwarze FWMR, Ribera J. Microbial production of melanin and its various applications. World J Microbiol Biotechnol. 2020;36(11):170. doi:10.1007/s11274-020-02941-z
CrossRef - Tran-Ly AN, Reyes C, Schwarze FWMR, Ribera J. Microbial production of melanin and its various applications. World J Microbiol Biotechnol. 2020;36(11):170. doi:10.1007/s11274-020-02941-z
CrossRef - Tsouko E, Tolia E, Sarris D. Microbial Melanin: Renewable Feedstock and Emerging Applications in Food-Related Systems. Sustainability. 2023;15(9):7516. doi:10.3390/su15097516
CrossRef - Barreto JV de O, Casanova LM, Junior AN, Reis-Mansur MCPP, Vermelho AB. Microbial Pigments: Major Groups and Industrial Applications. Microorganisms. 2023;11(12):2920. doi:10.3390/microorganisms11122920
CrossRef - El-Naggar NEA, Saber WIA. Natural Melanin: Current Trends, and Future Approaches, with Especial Reference to Microbial Source. Polymers (Basel). 2022;14(7):1339. doi:10.3390/polym14071339
CrossRef - Tran-Ly AN, Reyes C, Schwarze FWMR, Ribera J. Microbial production of melanin and its various applications. World J Microbiol Biotechnol. 2020;36(11):170. doi:10.1007/s11274-020-02941-z
CrossRef - Sharma R, Solanki P, Chaudhary M, Gupta N, Kaur P. Unveiling the potential of microalgae for bioplastic production from wastewater – current trends, innovations, and future prospects. Biotechnology for Sustainable Materials. 2024;1(1):10. doi:10.1186/s44316-024-00010-1
CrossRef - Ribera J, Panzarasa G, Stobbe A, et al. Scalable Biosynthesis of Melanin by the Basidiomycete Armillaria cepistipes. J Agric Food Chem. 2019;67(1):132-139. doi:10.1021/acs.jafc.8b05071
CrossRef - Alattas H, Glick BR, Murphy D V., Scott C. Harnessing Pseudomonas spp. for sustainable plant crop protection. Front Microbiol. 2024;15. doi:10.3389/fmicb.2024.1485197
CrossRef - Tran-Ly AN, Reyes C, Schwarze FWMR, Ribera J. Microbial production of melanin and its various applications. World J Microbiol Biotechnol. 2020;36(11):170. doi:10.1007/s11274-020-02941-z
CrossRef - Saini DK, Chakdar H, Pabbi S, Shukla P. Enhancing production of microalgal biopigments through metabolic and genetic engineering. Crit Rev Food Sci Nutr. 2020;60(3):391-405. doi:10.1080/10408398.2018.1533518
CrossRef - Guo L, Li W, Gu Z, et al. Recent Advances and Progress on Melanin: From Source to Application. Int J Mol Sci. 2023;24(5):4360. doi:10.3390/ijms24054360
CrossRef - Frank Anayo O, Chika Scholastica E, Chidi Peter O, Gray Nneji U, Obinna A, Oluwabusola Mistura L. The Beneficial Roles of Pseudomonas in Medicine, Industries, and Environment: A Review. In: Pseudomonas Aeruginosa – An Armory Within. IntechOpen; 2019. doi:10.5772/intechopen.85996
CrossRef - Muñoz-Torres P, Cárdenas-Ninasivincha S, Aguilar Y. Exploring the Agricultural Applications of Microbial Melanin. Microorganisms. 2024;12(7):1352. doi:10.3390/microorganisms12071352
CrossRef - Mavridi-Printezi A, Guernelli M, Menichetti A, Montalti M. Bio-Applications of Multifunctional Melanin Nanoparticles: From Nanomedicine to Nanocosmetics. Nanomaterials. 2020;10(11):2276. doi:10.3390/nano10112276
CrossRef - Kondakindi VR, Pabbati R, Erukulla P, Maddela NR, Prasad R. Bioremediation of heavy metals-contaminated sites by microbial extracellular polymeric substances – A critical view. Environmental Chemistry and Ecotoxicology. 2024;6:408-421. doi:10.1016/j.enceco.2024.05.002
CrossRef - Ozlu B, Ahmed MB, Muthoka RM, et al. Naturally derived electrically active materials for eco-friendly electronics. Mater Today Adv. 2024;21:100470. doi:10.1016/j.mtadv.2024.100470
CrossRef - Song W, Yang H, Liu S, et al. Melanin: insights into structure, analysis, and biological activities for future development. J Mater Chem B. 2023;11(32):7528-7543. doi:10.1039/D3TB01132A
CrossRef - Geeta Utekar* SI and SS. Isolation and Characterization of Melanin Producing Bacteria from Compost Soil. Bulletin of Environment, Pharmacology and Life Sciences. 2023;(1):265-268.
- Vera J, Alvarez R, Murano E, Slebe JC, Leon O. Identification of a Marine Agarolytic Pseudoalteromonas Isolate and Characterization of Its Extracellular Agarase. Appl Environ Microbiol. 1998;64(11):4378-4383. doi:10.1128/AEM.64.11.4378-4383.1998
CrossRef - Surwase SN, Jadhav SB, Phugare SS, Jadhav JP. Optimization of melanin production by Brevundimonas sp. SGJ using response surface methodology. 3 Biotech. 2013;3(3):187-194. doi:10.1007/s13205-012-0082-4
CrossRef - Kamarudheen N, Naushad T, Rao KVB. Biosynthesis, Characterization and Antagonistic Applications of Extracellular Melanin Pigment from Marine Nocardiopsis Sps. Indian Journal of Pharmaceutical Education and Research. 2019;53(2s):s112-s120. doi:10.5530/ijper.53.2s.55
CrossRef - Alam MZ, Ramachandran T, Antony A, Hamed F, Ayyash M, Kamal-Eldin A. Melanin is a plenteous bioactive phenolic compound in date fruits (Phoenix dactylifera L.). Sci Rep. 2022;12(1):6614. doi:10.1038/s41598-022-10546-9
CrossRef - Minasyan E, Aghajanyan A, Karapetyan K, et al. Antimicrobial Activity of Melanin Isolated from Wine Waste. Indian J Microbiol. 2024;64(4):1528-1534. doi:10.1007/s12088-023-01155-9
CrossRef - Baliyan S, Mukherjee R, Priyadarshini A, et al. Determination of Antioxidants by DPPH Radical Scavenging Activity and Quantitative Phytochemical Analysis of Ficus religiosa. Molecules. 2022;27(4):1326. doi:10.3390/molecules27041326
CrossRef - Micheal HSR, Thyagarajan D, Govindaraj M, Saravanakumar VK, Mohammed NB, Murugasamy Maheswari K. Biosorption of halophilic fungal melanized membrane – PUR/melanin polymer for heavy metal detoxification with electrospinning technology. Environ Technol. 2024;45(27):5865-5877. doi:10.1080/09593330.2024.2310034
CrossRef - Deepthi SS, K. MR, Mishra N, Agsar D. Melanin production by Pseudomonas sp. and in silico comparative analysis of tyrosinase gene sequences. BioTechnologia. 2021;102(4):411-424. doi:10.5114/bta.2021.111106
CrossRef - Ammanagi AI, C.T. S, R. K, et al. A biotechnological approach to optimization and production of melanin by Brevibacillus invocatus strain IBA, under submerged fermentation. Biomedicine (Taipei). 2022;42(2):318-324. doi:10.51248/.v42i2.1315
CrossRef - Pandey S, Meshram V, Yehia HM, Alzahrani A, Akhtar N, Sur A. Efficient production and characterization of melanin from Thermothelomyces hinnuleus SP1, isolated from the coal mines of Chhattisgarh, India. Front Microbiol. 2024;14. doi:10.3389/fmicb.2023.1320116
CrossRef - Naz Fuad Hama Khorshid, Nisreen Hadi Odaa. Extraction and Characterization of Melanin Pigment from Local Isolated Pseudomonas aeruginosa. Ibn-Al Haitham Journal for pure and applied sciences. 2025;38(2):82-92.
- Al Khatib M, Harir M, Costa J, et al. Spectroscopic Characterization of Natural Melanin from a Streptomyces cyaneofuscatus Strain and Comparison with Melanin Enzymatically Synthesized by Tyrosinase and Laccase. Molecules. 2018;23(8):1916. doi:10.3390/molecules23081916
CrossRef - Mathew D, G Bhat S. Pseudomonas Stutzeri as Biofactories for Melanin Nanoparticle Synthesis and Its Anti-Oxidative and Antibiofilm Potential Evaluation. Bionanoscience. 2022;12(3):912-926. doi:10.1007/s12668-022-01005-w
CrossRef - Eskandari S, Etemadifar Z. Isolation and Characterization of Melanin Producing Pseudomonas stutzeri Strain UIS2 in the Presence of l-tyrosine and Survey of Biological Properties of Its Melanin. Iranian Journal of Medical Microbiology. 2020;14(1):70-83. doi:10.30699/ijmm.14.1.70
CrossRef - El-Zawawy NA, Kenawy ER, Ahmed S, El-Sapagh S. Bioproduction and optimization of newly characterized melanin pigment from Streptomyces djakartensis NSS-3 with its anticancer, antimicrobial, and radioprotective properties. Microb Cell Fact. 2024;23(1):23. doi:10.1186/s12934-023-02276-y
CrossRef - Fatima M, Anuradha K. Isolation, Characterization, and Optimization Studies of Bacterial Pigments. J Pure Appl Microbiol. 2022;16(2):1039-1048. doi:10.22207/JPAM.16.2.28
CrossRef - Pralea IE, Moldovan RC, Petrache AM, et al. From Extraction to Advanced Analytical Methods: The Challenges of Melanin Analysis. Int J Mol Sci. 2019;20(16):3943. doi:10.3390/ijms20163943
CrossRef - Singh D, Deepshikha, Chaturvedi V, Verma P. The amazing world of biological pigments: A review on microbial melanins. Dyes and Pigments. 2025;237:112711. doi:10.1016/j.dyepig.2025.112711
CrossRef - Pombeiro-Sponchiado SR, Sousa GS, Andrade JCR, Lisboa HF, Gonçalves RCR. Production of Melanin Pigment by Fungi and Its Biotechnological Applications. In: Melanin. InTech; 2017. doi:10.5772/67375
CrossRef
Accepted on: 12-03-2026
Second Review by: Dr. Husniye Kayalar
Final Approval by: Dr. Wagih Ghannam